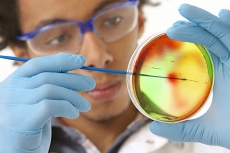

Tienes activado un bloqueador de publicidad
Intentamos presentarte publicidad respectuosa con el lector, que además ayuda a mantener este medio de comunicación y ofrecerte información de calidad.
Por eso te pedimos que nos apoyes y desactives el bloqueador de anuncios. Gracias.
Continuar...
Ciencia
RSS